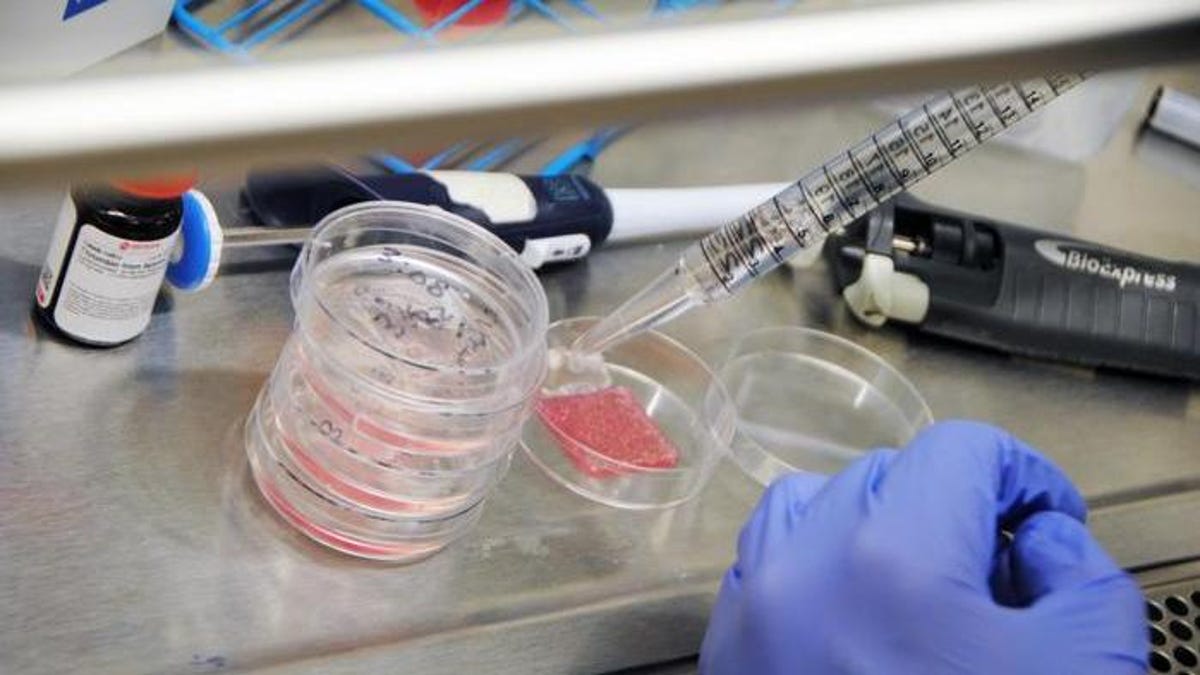
Featured image for Advancements in Bioprinting: Human-like Skin Revolutionizes Wound Healing

Innovative 3D-Printed Artificial Skin with Blood Circulation
Swedish researchers have developed innovative 3D bioprinting techniques to create artificial skin with blood vessels, potentially revolutionizing treatment for severe burns and trauma by enabling more functional skin regeneration.